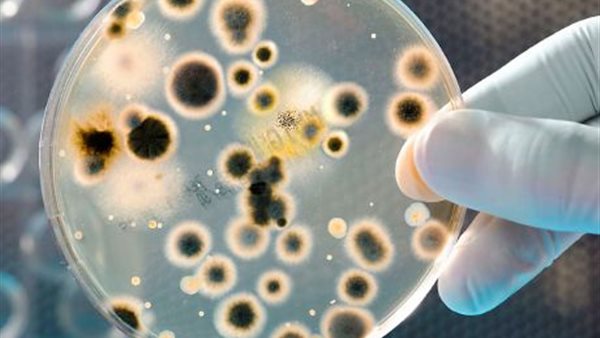
القاهرة 24

“آكلة لحوم البشر”.. ظهور بكتريا خطيرة تهدد الحياة بسبب ارتفاع درجات الحرارة
كشفت دراسة حديثة نوع خطير من البكتيريا آكلة للحوم، في مناطق جديدة بالولايات المتحدة الأمريكية، وذلك بسبب تغير المناخ المتصاعد حول العالم.
وأشارت الدراسة أن البكتيريا الآكلة للحوم، كونت نتيجة ارتفاع الحرارة في المياه، وتصيب فقط من يتناول كائنات قشرية من مياهه، مثل المحار النييء، حسب مجلة “بيزنس إنسايدر” الأمريكية.
Woman contracts flesh-eating bacteria in Gulf of Mexico; how to avoid Vibrio vulnificus https://t.co/kW82KTyDiH pic.twitter.com/ux8SoFRZXf
— AJC (@ajc) July 6, 2017
وأكدت مقدمة الدراسة، أنها لاحظت ارتفاع في عدد المصابين بالتهابات جلدية نتيجة البكتيريا الآكلة للحوم، والتي وصل عددها إلى خمس إصابات، بداية من 3 حالات في 2017 وحالتين في 2018.
ومن أبرز الأعراض الناتجة عن الإصابة بالبكتيريا الآكلة للحوم، تليف الأنسجة، وقد تؤدي في بعض الأحيان إلى بتر الأطراف.
وأضافت إن من بين المرضى الخمسة المذكورين في تقريرها، تم إزالة الأنسجة المصابة من ثلاثة منهم، بينما بترت سيقان ويدين مريض واحد، وتوفي آخر في المستشفى، وتأثيرها يكون أشد على من يعانون من أمراض سابقة، مثل أمراض الكبد والسكري.



















